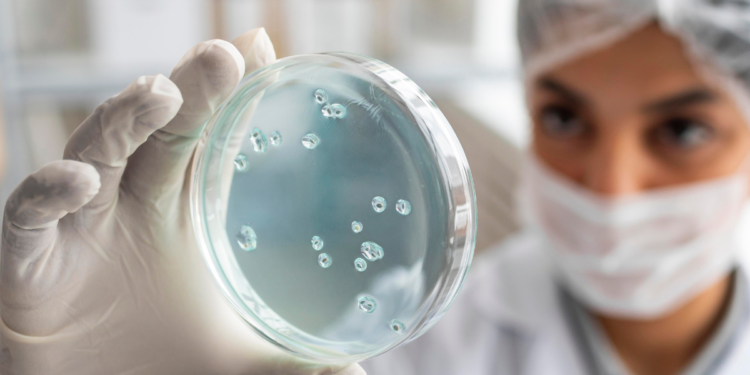
Cuidado ao nadar: ameba que come o cérebro humano já apareceu no Brasil

Cuidado ao entrar na água: uma ameba rara, capaz de provocar uma infecção grave no cérebro humano, já foi identificada no Brasil e acende um alerta entre autoridades de saúde e especialistas.
O micro-organismo se chama Naegleria fowleri e vive principalmente em água doce quente, como lagoas, rios e reservatórios naturais, sobretudo em períodos de altas temperaturas.
O que se sabe sobre a ameba e os riscos de infecção
No Brasil, o Ministério da Saúde confirmou recentemente a morte de uma criança no Ceará causada pela infecção. O caso ocorreu em Caucaia, na região metropolitana de Fortaleza, e envolveu um menino de um ano e três meses, que faleceu em setembro de 2024. A confirmação laboratorial da causa só ocorreu meses depois, após análises especializadas.
A Naegleria fowleri entra no organismo exclusivamente pelo nariz, quando a água contaminada é aspirada. A ameba migra pelas vias nasais até o cérebro, onde provoca a meningoencefalite amebiana primária, uma inflamação severa e de rápida progressão. Beber a água ou ter contato com a pele não causa infecção, segundo autoridades sanitárias.
A doença é considerada extremamente rara, mas quase sempre fatal. Dados internacionais apontam pouco mais de uma centena de casos registrados em décadas de monitoramento. A maioria das infecções está associada a atividades recreativas, como mergulhos, natação submersa ou brincadeiras em água quente e parada.
Os primeiros sintomas costumam surgir poucos dias após a exposição e incluem febre, dor de cabeça intensa, náuseas e vômitos. Com a evolução do quadro, podem aparecer rigidez no pescoço, confusão mental, convulsões e coma.
Ainda não existe tratamento totalmente eficaz, embora alguns sobreviventes tenham sido registrados com diagnóstico e intervenção muito precoces. Especialistas recomendam evitar mergulhos em água morna parada, usar clipes nasais e buscar atendimento imediato diante de sintomas neurológicos após contato aquático suspeito recente grave.